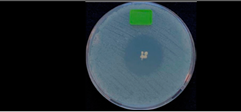
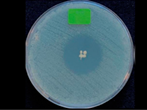
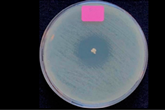
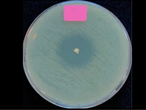

Physico-Chemical Characterizations of Composited Calcium-Ortho-Phosphate Porous Particles and Their Controlled Release Behavior of Clindamycin Phosphate and Amikacin Sulfate
Abstract
1. Introduction
2. Materials and Methods
2.1. Materials
2.2. Fabrication of Composited Calcium–Ortho-Phosphate Porous Particles
2.3. Characterization of Composited Calcium–Ortho-Phosphate Porous Particle
2.4. In Vitro Degradation
2.5. Drug Loading
2.6. In Vitro Drug Release
2.7. Antibacterial Activity of the Released Drug from the Particles
2.8. Statistical Analysis
3. Results and Discussion
3.1. Characteristics of Composited Calcium–Ortho-Phosphate Porous Particles
3.2. In Vitro Degradation of Composited Calcium–Ortho-Phosphate Porous Particle
3.3. Drug Loading and Entrapment Efficiency of the Particles
3.4. In Vitro Drug Release of CDP or AMK from the Particles
3.5. Antibacterial Activity of the Released Drug
4. Conclusions
Author Contributions
Funding
Institutional Review Board Statement
Data Availability Statement
Acknowledgments
Conflicts of Interest
References
- Makvandi, P.; Josic, U.; Delfi, M.; Pinelli, F.; Jahed, V.; Kaya, E.; Ashrafizadeh, M.; Zarepour, A.; Rossi, F.; Zarrabi, A. Drug delivery (nano) platforms for oral and dental applications: Tissue regeneration, infection control, and cancer management. Adv. Sci. 2021, 8, 2004014. [Google Scholar] [CrossRef]
- Zalavras, C.G.; Patzakis, M.J.; Holtom, P. Local antibiotic therapy in the treatment of open fractures and osteomyelitis. Clin. Orthop. Relat. Res. (1976–2007) 2004, 427, 86–93. [Google Scholar] [CrossRef] [PubMed]
- Karaglani, M.; Tzitzikou, E.; Tottas, S.; Kougioumtzis, I.; Arvanitidis, K.; Kolios, G.; Chatzaki, E.; Drosos, G.I. Gentamycin elution from polymethylmethacrylate and bone graft substitute: Comparison between commercially available and home-made preparations. J. Orthop. 2020, 19, 9–13. [Google Scholar] [CrossRef] [PubMed]
- Shah, S.R.; Tatara, A.M.; Lam, J.; Lu, S.; Scott, D.W.; Bennett, G.N.; van den Beucken, J.J.; Jansen, J.A.; Wong, M.E.; Mikos, A.G. Polymer-based local antibiotic delivery for prevention of polymicrobial infection in contaminated mandibular implants. ACS Biomater. Sci. Eng. 2016, 2, 558–566. [Google Scholar] [CrossRef] [PubMed]
- Van de Belt, H.; Neut, D.; Schenk, W.; Horn, J.R.V.; Mei, H.C.v.D.; Busscher, H.J. Gentamicin release from polymethylmethacrylate bone cements and Staphylococcus aureus biofilm formation. Acta Orthop. Scand. 2000, 71, 625–629. [Google Scholar] [CrossRef]
- Altman, G.H.; Diaz, F.; Jakuba, C.; Calabro, T.; Horan, R.L.; Chen, J.; Lu, H.; Richmond, J.; Kaplan, D.L. Silk-based biomaterials. Biomaterials 2003, 24, 401–416. [Google Scholar] [CrossRef]
- Melke, J.; Midha, S.; Ghosh, S.; Ito, K.; Hofmann, S. Silk fibroin as biomaterial for bone tissue engineering. Acta Biomater. 2016, 31, 1–16. [Google Scholar] [CrossRef]
- Sapudom, J.; Kongsema, M.; Methachittipan, A.; Damrongsakkul, S.; Kanokpanont, S.; Teo, J.C.; Khongkow, M.; Tonsomboon, K.; Thongnuek, P. Degradation products of crosslinked silk fibroin scaffolds modulate the immune response but not cell toxicity. J. Mater. Chem. B 2023, 11, 3607–3616. [Google Scholar] [CrossRef]
- Lerdchai, K.; Kitsongsermthon, J.; Ratanavaraporn, J.; Kanokpanont, S.; Damrongsakkul, S. Thai silk fibroin/gelatin sponges for the dual controlled release of curcumin and docosahexaenoic acid for anticancer treatment. J. Pharm. Sci. 2016, 105, 221–230. [Google Scholar] [CrossRef]
- Ratanavaraporn, J.; Kanokpanont, S.; Damrongsakkul, S. The development of injectable gelatin/silk fibroin microspheres for the dual delivery of curcumin and piperine. J. Mater. Sci. Mater. Med. 2014, 25, 401–410. [Google Scholar] [CrossRef]
- Tungtasana, H.; Shuangshoti, S.; Shuangshoti, S.; Kanokpanont, S.; Kaplan, D.L.; Bunaprasert, T.; Damrongsakkul, S. Tissue response and biodegradation of composite scaffolds prepared from Thai silk fibroin, gelatin and hydroxyapatite. J. Mater. Sci. Mater. Med. 2010, 21, 3151–3162. [Google Scholar] [CrossRef]
- Dille, M.; Haug, I.; Draget, K. Gelatin and collagen. In Handbook of Hydrocolloids, 3rd ed.; Elsevier: Amsterdam, The Netherlands, 2021; pp. 1073–1097. [Google Scholar] [CrossRef]
- Uyen, N.T.T.; Hamid, Z.A.A.; Tram, N.X.T.; Ahmad, N. Fabrication of alginate microspheres for drug delivery: A review. Int. J. Biol. Macromol. 2020, 153, 1035–1046. [Google Scholar] [CrossRef]
- Levingstone, T.J.; Herbaj, S.; Dunne, N.J. Calcium phosphate nanoparticles for therapeutic applications in bone regeneration. Nanomaterials 2019, 9, 1570. [Google Scholar] [CrossRef]
- Rauschmann, M.A.; Wichelhaus, T.A.; Stirnal, V.; Dingeldein, E.; Zichner, L.; Schnettler, R.; Alt, V. Nanocrystalline hydroxyapatite and calcium sulphate as biodegradable composite carrier material for local delivery of antibiotics in bone infections. Biomaterials 2005, 26, 2677–2684. [Google Scholar] [CrossRef]
- Roth, K.E.; Maier, G.S.; Schmidtmann, I.; Eigner, U.; Hübner, W.D.; Peters, F.; Drees, P.; Maus, U. Release of Antibiotics Out of a Moldable Collagen-β-Tricalciumphosphate-Composite Compared to Two Calcium Phosphate Granules. Materials 2019, 12, 4056. [Google Scholar] [CrossRef]
- Gowri, M.; Latha, N.; Suganya, K.; Murugan, M.; Rajan, M. Calcium alginate nanoparticle crosslinked phosphorylated polyallylamine to the controlled release of clindamycin for osteomyelitis treatment. Drug Dev. Ind. Pharm. 2021, 47, 280–291. [Google Scholar] [CrossRef] [PubMed]
- Pradid, J.; Keawwatana, W.; Boonyang, U.; Tangbunsuk, S. Biological properties and enzymatic degradation studies of clindamycin-loaded PLA/HAp microspheres prepared from crocodile bones. Polym. Bull. 2017, 74, 5181–5194. [Google Scholar] [CrossRef]
- Kilicarslan, M.; Ilhan, M.; Inal, O.; Orhan, K. Preparation and evaluation of clindamycin phosphate loaded chitosan/alginate polyelectrolyte complex film as mucoadhesive drug delivery system for periodontal therapy. Eur. J. Pharm. Sci. 2018, 123, 441–451. [Google Scholar] [CrossRef]
- Pahlevanzadeh, F.; Bakhsheshi-Rad, H.; Kasiri-Asgarani, M.; Emadi, R.; Omidi, M.; Ismail, A.; Afrand, M.; Berto, F. Mechanical property, antibacterial activity and cytocompatibility of a PMMA-based bone cement loaded with clindamycin for orthopaedic surgeries. Mater. Technol. 2021, 36, 564–573. [Google Scholar] [CrossRef]
- Tanha, N.R.; Nouri, M. Core-shell nanofibers of silk fibroin/polycaprolactone-clindamycin: Study on nanofibers structure and controlled release behavior. Polym. Sci. Ser. A 2019, 61, 85–95. [Google Scholar] [CrossRef]
- Mohamed, M.A.; Nasr, M.; Elkhatib, W.F.; Eltayeb, W.N. In vitro evaluation of antimicrobial activity and cytotoxicity of different nanobiotics targeting multidrug resistant and biofilm forming Staphylococci. BioMed. Res. Int. 2018, 2018, 7658238. [Google Scholar] [CrossRef] [PubMed]
- Vukomanović, M.; Zavašnik-Bergant, T.; Bračko, I.; Škapin, S.D.; Ignjatović, N.; Radmilović, V.; Uskoković, D. Poly(D,L-lactide-co-glycolide)/hydroxyapatite core-shell nanospheres, Part 3: Properties of hydroxyapatite nano-rods and investigation of a distribution of the drug within the composite. Colloids Surf. B Biointerfaces 2011, 87, 226–235. [Google Scholar] [CrossRef] [PubMed]
- Glinka, M.; Filatova, K.; Kucińska-Lipka, J.; Bergerova, E.D.; Wasik, A.; Sedlařík, V. Encapsulation of Amikacin into Microparticles Based on Low-Molecular-Weight Poly(lactic acid) and Poly(lactic acid-co-polyethylene glycol). Mol. Pharm. 2021, 18, 2986–2996. [Google Scholar] [CrossRef]
- Abbasi, A.R.; Sohail, M.; Minhas, M.U.; Khaliq, T.; Kousar, M.; Khan, S.; Hussain, Z.; Munir, A. Bioinspired sodium alginate based thermosensitive hydrogel membranes for accelerated wound healing. Int. J. Biol. Macromol. 2020, 155, 751–765. [Google Scholar] [CrossRef] [PubMed]
- Noel, S.P.; Courtney, H.S.; Bumgardner, J.D.; Haggard, W.O. Chitosan sponges to locally deliver amikacin and vancomycin: A pilot in vitro evaluation. Clin. Orthop. Relat. Res. 2010, 468, 2074–2080. [Google Scholar] [CrossRef] [PubMed]
- Nishimoto, K.; Kobayashi, M.; Nishikimi, N.; Komori, K.; Yamamura, K.; Fukase, F. Subcutaneous tissue release of amikacin from a fibrin glue/polyurethane graft. J. Infect. Chemother. 2004, 10, 101–104. [Google Scholar] [CrossRef]
- ISO 10993-13; Biological Evaluation of Medical Devices. In Part 13: Identification and Quantification of Degradation Products from Polymeric Medical Devices. International Organization for Standardization: Geneva, Switzerland, 2010. Available online: https://www.iso.org/standard/44050.html (accessed on 3 October 2024).
- ISO 10993-14; Biological Evaluation Of Medical Devices. In Part 14: Identification and Quantification of Degradation Products from Ceramics. International Organizationfor Standardization: Geneva, Switzerland, 2001. Available online: https://www.iso.org/standard/22693.html (accessed on 3 October 2024).
- Clinical and Laboratory Standards Institute (CLIS). Performance Standards for Antimocrobial Susceptibility Testing. In CLIS supplement M100; Clinical and Laboratory Standards Institute (CLIS): Malvern, PA, USA, 2020; Available online: https://www.nih.org.pk/wp-content/uploads/2021/02/CLSI-2020.pdf (accessed on 3 October 2024).
- Xidaki, D.; Agrafioti, P.; Diomatari, D.; Kaminari, A.; Tsalavoutas-Psarras, E.; Alexiou, P.; Psycharis, V.; Tsilibary, E.C.; Silvestros, S.; Sagnou, M. Synthesis of hydroxyapatite, β-tricalcium phosphate and biphasic calcium phosphate particles to act as local delivery carriers of curcumin: Loading, release and in vitro studies. Materials 2018, 11, 595. [Google Scholar] [CrossRef]
- Wu, Z.; Zhao, M.; Zhang, W.; Yang, Z.; Xu, S.; Shang, Q. Influence of drying processes on the structures, morphology and in vitro release profiles of risperidone-loaded PLGA microspheres. J. Microencapsul. 2019, 36, 21–31. [Google Scholar] [CrossRef]
- Sharma, C.; Dinda, A.K.; Potdar, P.D.; Mishra, N.C. Fabrication of quaternary composite scaffold from silk fibroin, chitosan, gelatin, and alginate for skin regeneration. J. Appl. Polym. Sci. 2015, 132, 1–12. [Google Scholar] [CrossRef]
- Foox, M.; Raz-Pasteur, A.; Berdicevsky, I.; Krivoy, N.; Zilberman, M. In vitro microbial inhibition, bonding strength, and cellular response to novel gelatin-alginate antibiotic-releasing soft tissue adhesives. Polym. Adv. Technol. 2014, 25, 516–524. [Google Scholar] [CrossRef]
- Insuasti-Cruz, E.; Suárez-Jaramillo, V.; Mena Urresta, K.A.; Pila-Varela, K.O.; Fiallos-Ayala, X.; Dahoumane, S.A.; Alexis, F. Natural biomaterials from biodiversity for healthcare applications. Adv. Healthc. Mater. 2022, 11, 2101389. [Google Scholar] [CrossRef] [PubMed]
- Lan, Y.; Li, W.; Guo, R.; Zhang, Y.; Xue, W.; Zhang, Y. Preparation and characterisation of vancomycin-impregnated gelatin microspheres/silk fibroin scaffold. J. Biomater. Sci. Polym. Ed. 2014, 25, 75–87. [Google Scholar] [CrossRef] [PubMed]
- Motta, A.; Fambri, L.; Migliaresi, C. Regenerated silk fibroin films: Thermal and dynamic mechanical analysis. Macromol. Chem. Phys. 2002, 203, 1658–1665. [Google Scholar] [CrossRef]
- Zhao, W.; Qi, Y.; Wang, Y.; Xue, Y.; Xu, P.; Li, Z.; Li, Q. Morphology and thermal properties of calcium alginate/reduced graphene oxide composites. Polymers 2018, 10, 990. [Google Scholar] [CrossRef]
- Wang, Y.; Fan, S.; Li, Y.; Niu, C.; Li, X.; Guo, Y.; Zhang, J.; Shi, J.; Wang, X. Silk fibroin/sodium alginate composite porous materials with controllable degradation. Int. J. Biol. Macromol. 2020, 150, 1314–1322. [Google Scholar] [CrossRef]
- Kao, H.H.; Kuo, C.Y.; Chen, K.S.; Chen, J.P. Preparation of gelatin and gelatin/hyaluronic acid cryogel scaffolds for the 3D culture of mesothelial cells and mesothelium tissue regeneration. Int. J. Mol. Sci. 2019, 20, 4527. [Google Scholar] [CrossRef]
- Lee, K.Y.; Mooney, D.J. Alginate: Properties and biomedical applications. Prog. Polym. Sci. 2012, 37, 106–126. [Google Scholar] [CrossRef]
- Dorozhkin, S.V. Calcium orthophosphate-based bioceramics. Materials 2013, 6, 3840–3942. [Google Scholar] [CrossRef]
- Eliaz, N.; Metoki, N. Calcium phosphate bioceramics: A review of their history, structure, properties, coating technologies and biomedical applications. Materials 2017, 10, 334. [Google Scholar] [CrossRef]
- He, F.; Ren, W.; Tian, X.; Liu, W.; Wu, S.; Chen, X. Comparative study on in vivo response of porous calcium carbonate composite ceramic and biphasic calcium phosphate ceramic. Mater. Sci. Eng. C 2016, 64, 117–123. [Google Scholar] [CrossRef]
- Maleki Dizaj, S.; Lotfipour, F.; Barzegar-Jalali, M.; Zarrintan, M.-H.; Adibkia, K. Ciprofloxacin HCl-loaded calcium carbonate nanoparticles: Preparation, solid state characterization, and evaluation of antimicrobial effect against Staphylococcus aureus. Artif. Cells Nanomed. Biotechnol. 2017, 45, 535–543. [Google Scholar] [CrossRef] [PubMed]
- Shen, S.; Wu, Y.; Liu, Y.; Wu, D. High drug-loading nanomedicines: Progress, current status, and prospects. Int. J. Nanomed. 2017, 12, 4085–4109. [Google Scholar] [CrossRef]
- Artioli, Y. Adsorption. In Encyclopedia of Ecology; Jørgensen, S.E., Fath, B.D., Eds.; Academic Press: Oxford, UK, 2008; pp. 60–65. [Google Scholar] [CrossRef]
- Tamaddon, L.; Mostafavi, S.A.; Karkhane, R.; Riazi-Esfahani, M.; Dorkoosh, F.A.; Rafiee-Tehrani, M. Thermoanalytical characterization of clindamycin-loaded intravitreal implants prepared by hot melt extrusion. Adv. Biomed. Res. 2015, 4, 147. [Google Scholar]
- Mohammadzadehmoghadam, S.; Dong, Y. Fabrication and characterization of electrospun silk fibroin/gelatin scaffolds crosslinked with glutaraldehyde vapor. Front. Mater. 2019, 6, 91. [Google Scholar] [CrossRef]
- Afriani, F.; Dahlan, K.; Nikmatin, S.; Zuas, O. Alginate affecting the characteristics of porous beta-TCP/alginate composite scaffolds. J. Optoelectron. Biomed. Mater. 2015, 7, 67–76. [Google Scholar]
- Berzina-Cimdina, L.; Borodajenko, N. Research of calcium phosphates using Fourier transform infrared spectroscopy. Infrared Spectrosc.-Mater. Sci. Eng. Technol. 2012, 12, 251–263. [Google Scholar]
- Egle, K.; Skadins, I.; Grava, A.; Micko, L.; Dubniks, V.; Salma, I.; Dubnika, A. Injectable Platelet-Rich Fibrin as a Drug Carrier Increases the Antibacterial Susceptibility of Antibiotic-Clindamycin Phosphate. Int. J. Mol. Sci. 2022, 23, 7407. [Google Scholar] [CrossRef]
- Knani, D.; Foox, M.; Zilberman, M. Simulation of the bioadhesive gelatin-alginate conjugate loaded with antibiotic drugs. Polym. Adv. Technol. 2019, 30, 519–528. [Google Scholar] [CrossRef]
- Słota, D.; Piętak, K.; Florkiewicz, W.; Jampílek, J.; Tomala, A.; Urbaniak, M.M.; Tomaszewska, A.; Rudnicka, K.; Sobczak-Kupiec, A. Clindamycin-loaded nanosized calcium phosphates powders as a carrier of active substances. Nanomaterials 2023, 13, 1469. [Google Scholar] [CrossRef]
- Heriot, M.; Nottelet, B.; Garric, X.; d’Este, M.; Richards, G.R.; Moriarty, F.T.; Eglin, D.; Guillaume, O. Interaction of gentamicin sulfate with alginate and consequences on the physico-chemical properties of alginate-containing biofilms. Int. J. Biol. Macromol. 2019, 121, 390–397. [Google Scholar] [CrossRef]
- United States Pharmacopeial Convention. 〈711〉 DISSOLUTION. In USP 40-NF 35; United States Pharmacopeial Convention, Incorporated: Frederick, MD, USA, 2009; pp. 1–15. Available online: https://www.usp.org/harmonization-standards/pdg/general-methods/dissolution (accessed on 3 October 2024).
- Guidance for Industry: Dissolution Testing and Acceptance Criteria for Immediate-Release Solid Oral Dosage Form Drug Products Containing High Solubility Drug Substances; U.S. Department of Health and Human Services Food: Washington, DC, USA; Drug Administration Center for Drug Evaluation and Research (CDER): Beltsville, MD, USA, 2018. Available online: https://www.fda.gov/drugs/guidance-compliance-regulatory-information/guidances-drugs (accessed on 3 October 2024).
- Rathbone, M.J.; Hadgraft, J.; Roberts, M.S.; Lane, M.E. Mathematical models of drug release. In Strategies to Modify the Drug Release from Pharmaceutical Systems; Bruschi, M.L., Ed.; Elsevier: Amsterdam, The Netherlands, 2008; pp. 63–86. [Google Scholar]
- Mah, E.; Ghosh, R. Thermo-responsive hydrogels for stimuli-responsive membranes. Processes 2013, 1, 238–262. [Google Scholar] [CrossRef]
- Ma, P.; Lai, X.; Luo, Z.; Chen, Y.; Loh, X.J.; Ye, E.; Li, Z.; Wu, C.; Wu, Y.-L. Recent advances in mechanical force-responsive drug delivery systems. Nanoscale Adv. 2022, 4, 3462–3478. [Google Scholar] [CrossRef] [PubMed]
- Maxwell, A.; Ghate, V.; Aranjani, J.; Lewis, S. Breaking the barriers for the delivery of amikacin: Challenges, strategies, and opportunities. Life Sci. 2021, 284, 119883. [Google Scholar] [CrossRef] [PubMed]
- Macha, I.J.; Ben-Nissan, B.; Vilchevskaya, E.N.; Morozova, A.S.; Abali, B.E.; Müller, W.H.; Rickert, W. Drug delivery from polymer-based nanopharmaceuticals-an experimental study complemented by simulations of selected diffusion processes. Front. Bioeng. Biotechnol. 2019, 7, 37. [Google Scholar] [CrossRef]
- Dash, S.; Murthy, P.N.; Nath, L.; Chowdhury, P. Kinetic modeling on drug release from controlled drug delivery systems. Acta Pol. Pharm.-Drug Res. 2010, 67, 217–223. [Google Scholar]

,
) and PBS (
,
), at pH 7.4 and 37 °C, according to ISO 10993-13. (b) Remaining weight of particles and total calcium (Ca) and phosphorus (P) in degradation solution (TRIS-HCI buffer solution
,
) at pH 7.4 and 37 °C, according to ISO 10993-14. Values reported are an average ± standard deviation (n = 3) and * indicates statistically significant differences at p < 0.05 between two degradation solutions at 56 days.
,
) and PBS (
,
), at pH 7.4 and 37 °C, according to ISO 10993-13. (b) Remaining weight of particles and total calcium (Ca) and phosphorus (P) in degradation solution (TRIS-HCI buffer solution
,
) at pH 7.4 and 37 °C, according to ISO 10993-14. Values reported are an average ± standard deviation (n = 3) and * indicates statistically significant differences at p < 0.05 between two degradation solutions at 56 days.




| Characteristics | Values | Method of Evaluation |
|---|---|---|
| Average sizes (n = 50) | Diameter (width) 2.78 ± 0.10 mm, (length) 3.19 ± 0.08 mm | SEM and Image J 1.53q software |
| Pore size (n = 50) | Macropores 100–900 µm Average size of 364 ± 72 µm | |
| Porosity (n = 50) | 69.36 ± 5.23% | |
| Total surface areas | 23.73 m2/g Micropore surface area 7.258 m2/g | BET |
| Density (n = 100) | 0.34 ± 0.02 g/cm3 | Average Volume/ Average Mass |
| Absorption | Approximately 500 times in PBS (pH 7.4, 37 °C) Within 30 min | - |
| Peak No. | Reference Wavenumber (cm−1) | Functional Group | Wavenumber (cm−1) | ||
|---|---|---|---|---|---|
| BP | CDP-BP | AMK-BP | |||
| 1 | 3200–3600 | O-H stretching | 3278 | 3275 | 3271 |
| 2 | 1620–1690 | amide I (C=O stretching) | 1624 | 1660 | 1623 |
| 3 | 1481–1550 | amide II (N-H bending) | 1524 | 1513 | 1525 |
| 4 | 1395–1440 | COO− | 1416 | 1421 | 1395 |
| 5 | 1200–1400 | amide III (C-N stretching) | 1214 | 1208 | 1213 |
| 6 | 1020–1120 560–600 | PO43− | 1026 | 1026 | 1022 |
| 599 | 598 | 599 | |||
| 559 | 553 | 551 | |||
| 7 | 720–730 | P2O74− | 725 | ||
| 8 | 2840–3000 | C-H stretching | - | 2955 | - |
| 9 | 2840–3000 | C-H stretching | - | 2923 | 2936 |
| 10 | 1209–1249 | S-C-H stretching | - | 1255 | - |
| - | 1208 | - | |||
| 11 | 1020–1250 | C-N (Stretching) (Aliphatic amine) | - | 1046 | - |
| 12 | 1000–1260 | C-O stretching | - | - | 1264 |
| Sample | Zero Order | First Order | Higuchi | Korsmeyer–Peppas | ||||
|---|---|---|---|---|---|---|---|---|
| k | R2 | k | R2 | k | R2 | R2 | n | |
| (mg/mL·h) | (h−1) | (mg/mL·h1/2) | ||||||
| 150 CDP | 0.0752 | 0.77 | 0.0199 | 0.94 | 0.7008 | 0.87 | 0.96 | 0.29 |
| 100 CDP | 0.0333 | 0.80 | 0.0221 | 0.96 | 0.3109 | 0.91 | 0.90 | 0.25 |
| 50 CDP | 0.0133 | 0.77 | 0.0226 | 0.96 | 0.1258 | 0.90 | 0.97 | 0.33 |
| 125 AMK | 0.0811 | 0.89 | 0.0251 | 0.99 | 0.7431 | 0.97 | 0.99 | 0.30 |
| 85 AMK | 0.0343 | 0.75 | 0.0260 | 0.99 | 0.3288 | 0.90 | 0.93 | 0.19 |
| 45 AMK | 0.0140 | 0.49 | 0.0270 | 0.76 | 0.1442 | 0.65 | 0.90 | 0.43 |
| Time | Photographs and Diameter of Clear Zone (mm) | |
|---|---|---|
| S. aureus | E. coli | |
| Control (Particle Only) | Control (Particle Only) | |
| 24 h | ![]() | ![]() |
| 0.00 ± 0.00 mm | 0.00 ± 0.00 mm | |
| CDP-BP | AMK-BP | |
| 24 h | ![]() | ![]() |
| 25.67 ± 1.53 a mm | 22.00 ± 0.00 b mm | |
| 48 h | ![]() | ![]() |
| 25.00 ± 1.00 a mm | 20.67 ± 1.15 b mm | |
| 72 h | ![]() | ![]() |
| 24.67 ± 1.15 a mm | 20.00 ± 0.00 b mm | |
Disclaimer/Publisher’s Note: The statements, opinions and data contained in all publications are solely those of the individual author(s) and contributor(s) and not of MDPI and/or the editor(s). MDPI and/or the editor(s) disclaim responsibility for any injury to people or property resulting from any ideas, methods, instructions or products referred to in the content. |
© 2024 by the authors. Licensee MDPI, Basel, Switzerland. This article is an open access article distributed under the terms and conditions of the Creative Commons Attribution (CC BY) license (https://creativecommons.org/licenses/by/4.0/).
Share and Cite
Khamkaew, N.; Kanokpanont, S.; Apinun, J.; Wangdee, C.; Motta, A.; Damrongsakkul, S. Physico-Chemical Characterizations of Composited Calcium-Ortho-Phosphate Porous Particles and Their Controlled Release Behavior of Clindamycin Phosphate and Amikacin Sulfate. Polymers 2024, 16, 3144. https://doi.org/10.3390/polym16223144
Khamkaew N, Kanokpanont S, Apinun J, Wangdee C, Motta A, Damrongsakkul S. Physico-Chemical Characterizations of Composited Calcium-Ortho-Phosphate Porous Particles and Their Controlled Release Behavior of Clindamycin Phosphate and Amikacin Sulfate. Polymers. 2024; 16(22):3144. https://doi.org/10.3390/polym16223144
Chicago/Turabian StyleKhamkaew, Namfon, Sorada Kanokpanont, Jirun Apinun, Chalika Wangdee, Antonella Motta, and Siriporn Damrongsakkul. 2024. "Physico-Chemical Characterizations of Composited Calcium-Ortho-Phosphate Porous Particles and Their Controlled Release Behavior of Clindamycin Phosphate and Amikacin Sulfate" Polymers 16, no. 22: 3144. https://doi.org/10.3390/polym16223144
APA StyleKhamkaew, N., Kanokpanont, S., Apinun, J., Wangdee, C., Motta, A., & Damrongsakkul, S. (2024). Physico-Chemical Characterizations of Composited Calcium-Ortho-Phosphate Porous Particles and Their Controlled Release Behavior of Clindamycin Phosphate and Amikacin Sulfate. Polymers, 16(22), 3144. https://doi.org/10.3390/polym16223144